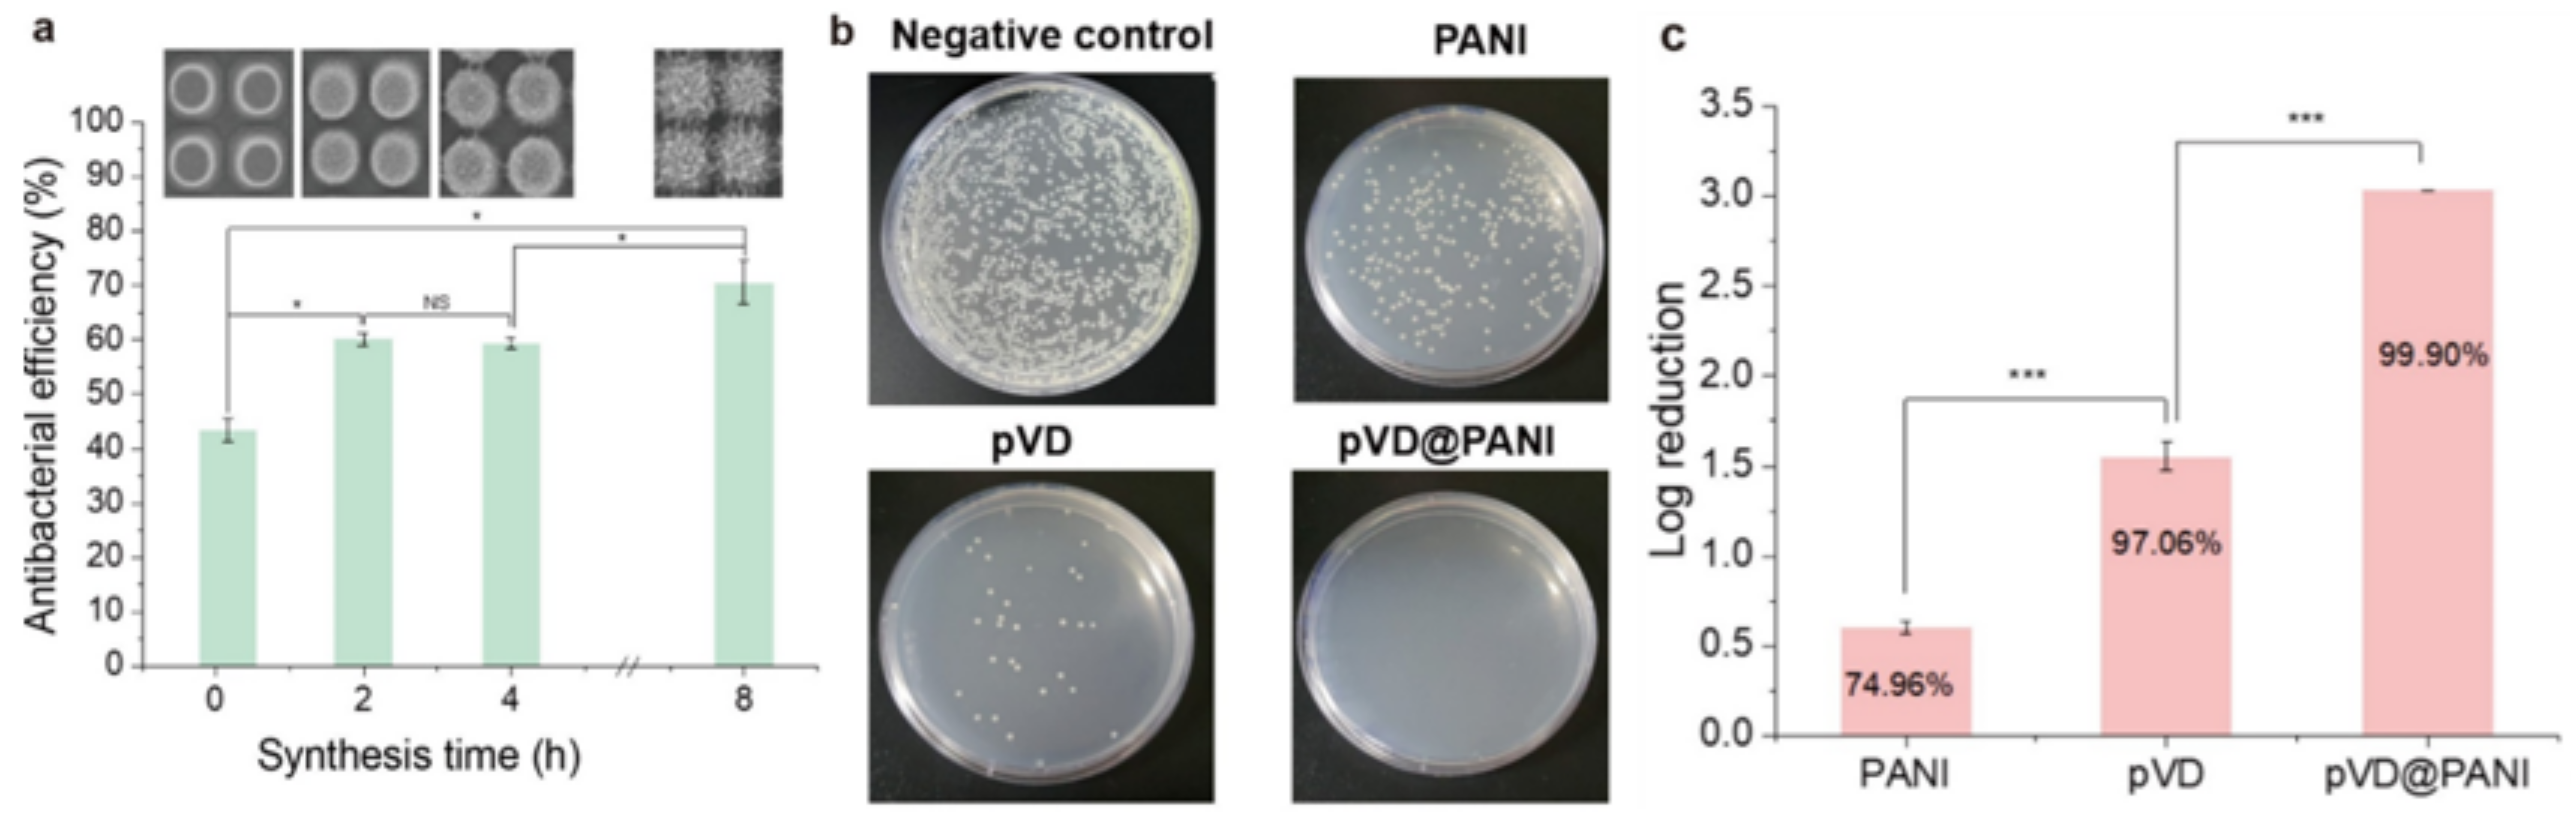
Nanomaterials 11 02716 g007 550

3D Hierarchical Polyaniline–Metal Hybrid Nanopillars: Morphological Control and Its Antibacterial Application
Abstract
:1. Introduction
2. Materials and Methods
2.1. Fabrication of a Si Master Mold
2.2. Preparation of a PANI Nanostructure
2.3. Antibacterial Coating
2.4. Preparation of an Antibacterial Test
2.5. Statistical Analysis
2.6. Characterizations
3. Results
3.1. Subsection Effect of Reaction Time on PANI Morphology
3.2. Effect of Reagents on PANI Structures
3.3. Synthesis Mechanism of PANI
3.4. Antibacterial Test
4. Conclusions
Supplementary Materials
Author Contributions
Funding
Institutional Review Board Statement
Data Availability Statement
Conflicts of Interest
References
- Hasan, J.; Crawford, R.; Ivanova, E.P. Antibacterial surfaces: The quest for a new generation of biomaterials. Trends Biotechnol. 2013, 31, 295–304. [Google Scholar] [CrossRef] [PubMed]
- Tripathy, A.; Pahal, S.; Mudakavi, R.J.; Raichur, A.M.; Varma, M.M.; Sen, P. Impact of Bioinspired Nanotopography on the Antibacterial and Antibiofilm Efficacy of Chitosan. Biomacromolecules 2018, 19, 1340–1346. [Google Scholar] [CrossRef] [PubMed]
- Ribet, D.; Cossart, P. How bacterial pathogens colonize their hosts and invade deeper tissues. Microbes Infect. 2015, 17, 173–183. [Google Scholar] [CrossRef] [PubMed]
- Siegel, S.J.; Weiser, J.N. Mechanisms of Bacterial Colonization of the Respiratory Tract. Annu. Rev. Microbiol. 2015, 69, 425–444. [Google Scholar] [CrossRef] [Green Version]
- Su, Y.; Wang, H.; Mishra, B.; Narayana, J.L.; Jiang, J.; Reilly, D.A.; Hollins, R.R.; Carlson, M.A.; Wang, G.; Xie, J. Nanofiber Dressings Topically Delivering Molecularly Engineered Human Cathelicidin Peptides for the Treatment of Biofilms in Chronic Wounds. Mol. Pharm. 2019, 16, 2011–2020. [Google Scholar] [CrossRef]
- Chen, C.-K.; Liao, M.-G.; Wu, Y.-L.; Fang, Z.-Y.; Chen, J.-A. Preparation of Highly Swelling/Antibacterial Cross-Linked N-Maleoyl-Functional Chitosan/Polyethylene Oxide Nanofiber Meshes for Controlled Antibiotic Release. Mol. Pharm. 2020, 17, 3461–3476. [Google Scholar] [CrossRef]
- Sirelkhatim, A.; Mahmud, S.; Seeni, A.; Kaus, N.H.M.; Ann, L.C.; Bakhori, S.K.M.; Hasan, H.; Mohamad, D. Review on Zinc Oxide Nanoparticles: Antibacterial Activity and Toxicity Mechanism. Nano-Micro Lett. 2015, 7, 219–242. [Google Scholar] [CrossRef] [Green Version]
- Vimbela, G.V.; Ngo, S.M.; Fraze, C.; Yang, L.; Stout, D.A. Antibacterial properties and toxicity from metallic nanomaterials. Int. J. Nanomed. 2017, 12, 3941. [Google Scholar] [CrossRef] [Green Version]
- Ingle, A.P.; Durán, N.; Rai, M. Bioactivity, mechanism of action, and cytotoxicity of copper-based nanoparticles: A review. Appl. Microbiol. Biotechnol. 2013, 98, 1001–1009. [Google Scholar] [CrossRef]
- Parra, F.; Vázquez, B.; Benito-Garzón, L.; Barcenilla, J.; Román, J.S. Foldable Antibacterial Acrylic Intraocular Lenses of High Refractive Index. Biomacromolecules 2009, 10, 3055–3061. [Google Scholar] [CrossRef]
- Wang, B.; Ye, Z.; Tang, Y.; Han, Y.; Lin, Q.; Liu, H.; Chen, H.; Nan, K. Fabrication of nonfouling, bactericidal, and bacteria corpse release multifunctional surface through surface-initiated RAFT polymerization. Int. J. Nanomed. 2016, ume 12, 111–125. [Google Scholar] [CrossRef] [Green Version]
- Pogodin, S.; Hasan, J.; Baulin, V.A.; Webb, H.; Truong, V.K.; Nguyen, T.H.P.; Boshkovikj, V.; Fluke, C.; Watson, G.; Watson, J.; et al. Biophysical Model of Bacterial Cell Interactions with Nanopatterned Cicada Wing Surfaces. Biophys. J. 2013, 104, 835–840. [Google Scholar] [CrossRef] [Green Version]
- Bandara, C.D.; Singh, S.; Afara, I.O.; Wolff, A.; Tesfamichael, T.; Ostrikov, K.; Oloyede, A. Bactericidal Effects of Natural Nanotopography of Dragonfly Wing on Escherichia coli. ACS Appl. Mater. Interfaces 2017, 9, 6746–6760. [Google Scholar] [CrossRef] [Green Version]
- Jenkins, J.; Mantell, J.; Neal, C.; Gholinia, A.; Verkade, P.; Nobbs, A.H.; Su, B. Antibacterial effects of nanopillar surfaces are mediated by cell impedance, penetration and induction of oxidative stress. Nat. Commun. 2020, 11, 1–14. [Google Scholar] [CrossRef]
- Lee, K.S.; Kim, C.H.; Jeong, S.W.; Song, Y.; Bae, N.H.; Lee, S.J.; Lee, K.G. Ultrasonic fabrication of flexible antibacterial ZnO nanopillar array film. Colloids Surfaces B Biointerfaces 2018, 170, 172–178. [Google Scholar] [CrossRef]
- Saveleva, M.S.; Eftekhari, K.; Abalymov, A.; Douglas, T.E.L.; Volodkin, D.; Parakhonskiy, B.V.; Skirtach, A.G. Hierarchy of Hybrid Materials—The Place of Inorganics-in-Organics in it, Their Composition and Applications. Front. Chem. 2019, 7, 179. [Google Scholar] [CrossRef] [Green Version]
- Silina, Y.E.; Gernaey, K.V.; Semenova, D.; Iatsunskyi, I. Application of Organic-Inorganic Hybrids in Chemical Analysis, Bio- and Environmental Monitoring. Appl. Sci. 2020, 10, 1458. [Google Scholar] [CrossRef] [Green Version]
- Liu, X.; Wu, Y.; Zhao, X.; Wang, Z. Fabrication and applications of bioactive chitosan-based organic-inorganic hybrid materials: A review. Carbohydr. Polym. 2021, 267, 118179. [Google Scholar] [CrossRef]
- Park, W.; Shin, H.; Choi, B.; Rhim, W.-K.; Na, K.; Han, D.K. Advanced hybrid nanomaterials for biomedical applications. Prog. Mater. Sci. 2020, 114, 100686. [Google Scholar] [CrossRef]
- Sasidharan, V.; Sachan, D.; Chauhan, D.; Talreja, N.; Ashfaq, M. Three-dimensional (3D) polymer—metal–carbon framework for efficient removal of chemical and biological contaminants. Sci. Rep. 2021, 11, 1–14. [Google Scholar] [CrossRef]
- Nishino, F.; Jeem, M.; Zhang, L.; Okamoto, K.; Okabe, S.; Watanabe, S. Formation of CuO nano-flowered surfaces via submerged photo-synthesis of crystallites and their antimicrobial activity. Sci. Rep. 2017, 7, 1–11. [Google Scholar] [CrossRef] [PubMed]
- Ermini, M.L.; Voliani, V. Antimicrobial Nano-Agents: The Copper Age. ACS Nano 2021, 15, 6008–6029. [Google Scholar] [CrossRef] [PubMed]
- Kim, K.H.; Hwang, A.; Song, Y.; Lee, W.S.; Moon, J.; Jeong, J.; Bae, N.H.; Jung, Y.M.; Jung, J.; Ryu, S.; et al. 3D Hierarchical Nanotopography for On-Site Rapid Capture and Sensitive Detection of Infectious Microbial Pathogens. ACS Nano 2021, 15, 4777–4788. [Google Scholar] [CrossRef] [PubMed]
- Lee, K.G.; Choi, B.G.; Kim, B.I.; Shyu, T.; Oh, M.S.; Im, S.G.; Chang, S.-J.; Lee, T.J.; Kotov, N.A.; Lee, S.J. Scalable Nanopillar Arrays with Layer-by-Layer Patterned Overt and Covert Images. Adv. Mater. 2014, 26, 6119–6124. [Google Scholar] [CrossRef] [PubMed] [Green Version]
- Choi, G.; Song, Y.; Lim, H.; Lee, S.H.; Lee, H.K.; Lee, E.; Choi, B.G.; Lee, J.J.; Im, S.G.; Lee, K.G. Antibacterial Nanopillar Array for an Implantable Intraocular Lens. Adv. Heal. Mater. 2020, 9, e2000447. [Google Scholar] [CrossRef] [PubMed]
- Choi, Y.; Song, Y.; Kim, Y.T.; Lee, S.J.; Lee, K.G.; Im, S.G. Multifunctional Printable Micropattern Array for Digital Nucleic Acid Assay for Microbial Pathogen Detection. ACS Appl. Mater. Interfaces 2021, 13, 3098–3108. [Google Scholar] [CrossRef] [PubMed]
- Song, Y.; Kim, Y.T.; Choi, Y.; Kim, H.; Yeom, M.H.; Kim, Y.; Lee, T.J.; Lee, K.G.; Im, S.G. All-in-One DNA Extraction Tube for Facilitated Real-Time Detection of Infectious Pathogens. Adv. Heal. Mater. 2021, 2100430. [Google Scholar] [CrossRef]
- Park, S.H.; Jeong, J.-M.; Kim, S.J.; Kim, K.H.; Lee, S.H.; Bae, N.H.; Lee, K.G.; Choi, B.G. Large-Area and 3D Polyaniline Nanoweb Film for Flexible Supercapacitors with High Rate Capability and Long Cycle Life. ACS Appl. Energy Mater. 2020, 3, 7746–7755. [Google Scholar] [CrossRef]
- Chiou, N.-R.; Epstein, A.J. Polyaniline Nanofibers Prepared by Dilute Polymerization. Adv. Mater. 2005, 17, 1679–1683. [Google Scholar] [CrossRef]
- Wang, P.-C.; Venancio, E.C.; Sarno, D.M.; MacDiarmid, A.G. Simplifying the reaction system for the preparation of polyaniline nanofibers: Re-examination of template-free oxidative chemical polymerization of aniline in conventional low-pH acidic aqueous media. React. Funct. Polym. 2009, 69, 217–223. [Google Scholar] [CrossRef]
- Stejskal, J.; Gilbert, R.G. Polyaniline. Preparation of a conducting polymer(IUPAC Technical Report). Pure Appl. Chem. 2002, 74, 857–867. [Google Scholar] [CrossRef] [Green Version]
- Chiang, J.-C.; MacDiarmid, A.G. ‘Polyaniline’: Protonic acid doping of the emeraldine form to the metallic regime. Synth. Met. 1986, 13, 193–205. [Google Scholar] [CrossRef]
- Sapurina, I.Y.; Shishov, M. Oxidative polymerization of aniline: Molecular synthesis of polyaniline and the formation of supramolecular structures. New Polym. Spec. Appl. 2012, 740, 272. [Google Scholar]
- Tang, S.-J.; Wang, A.-T.; Lin, S.-Y.; Huang, K.-Y.; Yang, C.-C.; Yeh, J.-M.; Chiu, K.-C. Polymerization of aniline under various concentrations of APS and HCl. Polym. J. 2011, 43, 667–675. [Google Scholar] [CrossRef] [Green Version]
- Wu, T.-F.; Hong, J.-D. Humidity sensing properties of transferable polyaniline thin films formed at the air–water interface. RSC Adv. 2016, 6, 96935–96941. [Google Scholar] [CrossRef]
- Vu, D.L.; Li, Y.-Y.; Lin, T.-H.; Wu, M.-C. Fabrication and humidity sensing property of UV/ozone treated PANI/PMMA electrospun fibers. J. Taiwan Inst. Chem. Eng. 2019, 99, 250–257. [Google Scholar] [CrossRef]
- Thanh, N.T.K.; MacLean, N.; Mahiddine, S. Mechanisms of Nucleation and Growth of Nanoparticles in Solution. Chem. Rev. 2014, 114, 7610–7630. [Google Scholar] [CrossRef]
- Hwang, N.M. Non-Classical Crystallization of Thin Films and Nanostructures in CVD and PVD Processes; Springer: Dordrecht, The Netherlands, 2016; Volume 60. [Google Scholar]
- Laslau, C.; Zujovic, Z.; Travas-Sejdic, J. Theories of polyaniline nanostructure self-assembly: Towards an expanded, comprehensive Multi-Layer Theory (MLT). Prog. Polym. Sci. 2010, 35, 1403–1419. [Google Scholar] [CrossRef]
- Stejskal, J.; Sapurina, I.; Trchova, M. Polyaniline nanostructures and the role of aniline oligomers in their formation. Prog. Polym. Sci. 2010, 35, 1420–1481. [Google Scholar] [CrossRef]
- Molapo, K.M.; Ndangili, P.M.; Ajayi, R.F.; Mbambisa, G.; Mailu, S.M.; Njomo, N.; Masikini, M.; Baker, P.; Iwuoha, E.I. Electronics of conjugated polymers (I): Polyaniline. Int. J. Electrochem. Sci. 2012, 7, 11859–11875. [Google Scholar]
- Nguyen, D.H.; Bazaka, O.; Bazaka, K.; Crawford, R.J.; Ivanova, E.P. Three-Dimensional Hierarchical Wrinkles on Polymer Films: From Chaotic to Ordered Antimicrobial Topographies. Trends Biotechnol. 2020, 38, 558–571. [Google Scholar] [CrossRef]
- Ferreira, S.; Piedade, A.P. Influence of Extracellular Mimicked Hierarchical Nano-Micro-Topography on the Bacteria/Abiotic Interface. Polymers 2020, 12, 828. [Google Scholar] [CrossRef] [Green Version]
- Wang, T.; Huang, L.; Liu, Y.; Li, X.; Liu, C.; Handschuh-Wang, S.; Xu, Y.; Zhao, Y.; Tang, Y. Robust Biomimetic Hierarchical Diamond Architecture with a Self-Cleaning, Antibacterial, and Antibiofouling Surface. ACS Appl. Mater. Interfaces 2020, 12, 24432–24441. [Google Scholar] [CrossRef]

| [Aniline] ≥ [Acid] | [Aniline] < [Acid] | |
|---|---|---|
| Oxidation of Monomer | Aniline radical | Anilinium cation |
| Re-aromatization | Phenazine-like oligomer | Para-coupled oligomer |
| pH | Weak acid (terminated) | Strong acid (terminated |
| Structure | Planar phenazine-like structure
| Many interchain/intrachain
|
| Shape | Nanosheet | Nanofiber or nanogranule |
Publisher’s Note: MDPI stays neutral with regard to jurisdictional claims in published maps and institutional affiliations. |
© 2021 by the authors. Licensee MDPI, Basel, Switzerland. This article is an open access article distributed under the terms and conditions of the Creative Commons Attribution (CC BY) license (https://creativecommons.org/licenses/by/4.0/).
Share and Cite
Kim, J.; Song, Y.; Kim, H.; Bae, N.-H.; Lee, T.J.; Park, Y.M.; Lee, S.J.; Im, S.G.; Choi, B.G.; Lee, K.G. 3D Hierarchical Polyaniline–Metal Hybrid Nanopillars: Morphological Control and Its Antibacterial Application. Nanomaterials 2021, 11, 2716. https://doi.org/10.3390/nano11102716
Kim J, Song Y, Kim H, Bae N-H, Lee TJ, Park YM, Lee SJ, Im SG, Choi BG, Lee KG. 3D Hierarchical Polyaniline–Metal Hybrid Nanopillars: Morphological Control and Its Antibacterial Application. Nanomaterials. 2021; 11(10):2716. https://doi.org/10.3390/nano11102716
Chicago/Turabian StyleKim, Jueun, Younseong Song, Hogi Kim, Nam-Ho Bae, Tae Jae Lee, Yoo Min Park, Seok Jae Lee, Sung Gap Im, Bong Gill Choi, and Kyoung G. Lee. 2021. "3D Hierarchical Polyaniline–Metal Hybrid Nanopillars: Morphological Control and Its Antibacterial Application" Nanomaterials 11, no. 10: 2716. https://doi.org/10.3390/nano11102716
APA StyleKim, J., Song, Y., Kim, H., Bae, N.-H., Lee, T. J., Park, Y. M., Lee, S. J., Im, S. G., Choi, B. G., & Lee, K. G. (2021). 3D Hierarchical Polyaniline–Metal Hybrid Nanopillars: Morphological Control and Its Antibacterial Application. Nanomaterials, 11(10), 2716. https://doi.org/10.3390/nano11102716

